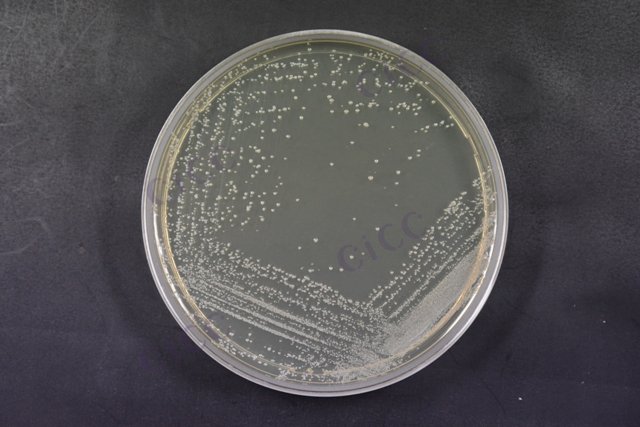
表皮葡萄球菌 Staphylococcus epidermidis CICC 10294 Staphylococcus epidermidis

表皮葡萄球菌 Staphylococcus epidermidis CICC 10294 Staphylococcus epidermidis
-
表皮葡萄球菌 Staphylococcus epidermidis CICC 10398 Staphylococcus epidermidis
CICC 10398 | 见证书
-
表皮葡萄球菌 Staphylococcus epidermidis CICC 10436 Staphylococcus epidermidis
CICC 10436 | 见证书
-
表皮葡萄球菌 Staphylococcus epidermidis CICC 10629 Staphylococcus epidermidis
CICC 10629 | 见证书
-
表皮葡萄球菌 Staphylococcus epidermidis CICC 11118s Staphylococcus epidermidis
CICC 11118s | 见证书
-
表皮葡萄球菌 Staphylococcus epidermidis CICC 25251 Staphylococcus epidermidis
CICC 25251 | 见证书
-
表皮葡萄球菌 Staphylococcus epidermidis CICC 6039 Staphylococcus epidermidis
CICC 6039 | 见证书
-
表皮葡萄球菌 Staphylococcus epidermidis CICC 25333 Staphylococcus epidermidis
CICC 25333 | 见证书

说明书下载: 菌种说明书 打管说明书
您正在浏览的产品:表皮葡萄球菌 Staphylococcus epidermidis CICC 10294
手机版:表皮葡萄球菌 Staphylococcus epidermidis CICC 10294
本公司销售的所有产品仅供实验科研使用,不用于人体及临床诊断。
2. 分离培养:接种血琼脂平板及高盐甘露醇平板,35-37℃培养18-24小时;
3. 鉴定:通过菌落形态、革兰染色、触酶试验及凝固酶试验分步确认[1][8]。
2. 耐药性检测推荐补充药敏试验(如CLSI标准);
3. 高盐环境下可能抑制部分竞争菌生长,但不影响目标菌检出[1][8]。
以上信息仅供参考,请以相应标准的原文为准!